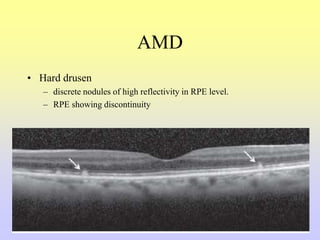
AMD
• Hard drusen
– discrete nodules of high reflectivity in RPE level.
– RPE showing discontinuity
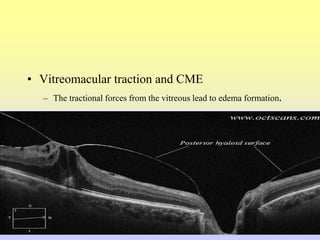
• Vitreomacular traction and CME
– The tractional forces from the vitreous lead to edema formation.

OCT is used to non-invasively image the retina in cross-section with micrometer-level resolution. It works by measuring the interference of light reflected from retinal structures. OCT was developed in 1991 and uses near-infrared light wavelengths of 840nm and 1310nm. OCT provides high-resolution 2D images of the retina and can integrate data points over depth to form 3D representations. It is useful for diagnosing and monitoring many retinal diseases.